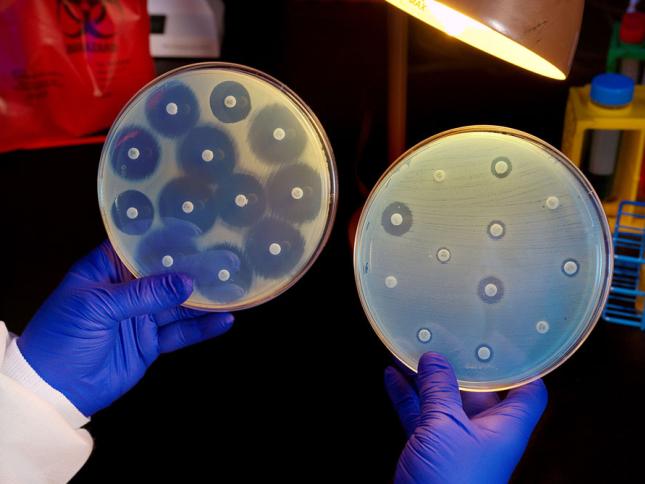

در سال ۲۰۱۹، بیش از یک میلیون و ۲۰۰ هزار نفر در اثر عفونتهای ناشی از باکتریهای مقاوم در برابر داروهای آنتیبیوتیک جان باختند
این اعانات صرف کمک به کشورهای فقیر در مقابله با پیامدهای کرونا خواهد شد